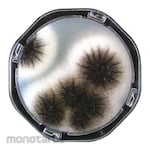
Eiken Chemical Petancheck RII25

Beli harga potato dextrose agar di monotaro.id
Kami Menampilkan Rekomendasi Kami Untuk Anda! Anda Bisa Membelinya Kapan Saja di monotaro.id
- Biokar Potato Dextrose AgarDeskripsi:Biokar Potato dextrose agar BK095HAatribut:
- Packaging Size (g): 500
- Product Type: Consumables
- format: Dehydrated Culture Media
- Mister Potato Crips Keripik KentangDeskripsi:Mister Potato Crisps Original 85grKeripik kentang yang terbuat dari kentang pilihan berkualitas tinggi, diolah dengan teknologi modern. Rasa kentang asli dan renyahnya selalu bikin seru waktu dimakan sendiri atau barengan.Komposisi: Kentang Kering, Minyak Nabati ( Mengandung Antioksidan TBHQ (E391)), Tapioka Starch, Dextrose, Penguat Rasa Mononatrium Glutamat, Lada Putih Bubuk, Garam, Gula.atribut:
- Size (g): 85
- AS ONE Powder Mediumatribut:
- Capacity (g): 300
- Storage Method: Light-resistant/R.T. Storage
- Eiken Chemical Petancheck RII25atribut:
- Storage Method Temperature (°C): 2 to 10 (no light or freezing)
- Medium Surface Area (cm²): 25
Daftar Harga harga potato dextrose agar Terbaru November 2025
| Biokar Potato Dextrose Agar | Rp2.699.900 |
| Mister Potato Crips Keripik Kentang | Rp219.900 |
| AS ONE Powder Medium | Rp1.299.900 |
| Merck Millipore Powder Medium | Rp4.799.900 |
| Eiken Chemical Petancheck RII25 | Rp1.799.900 |
Data diperbarui pada 05/11/2025 (Harga belum termasuk PPN)